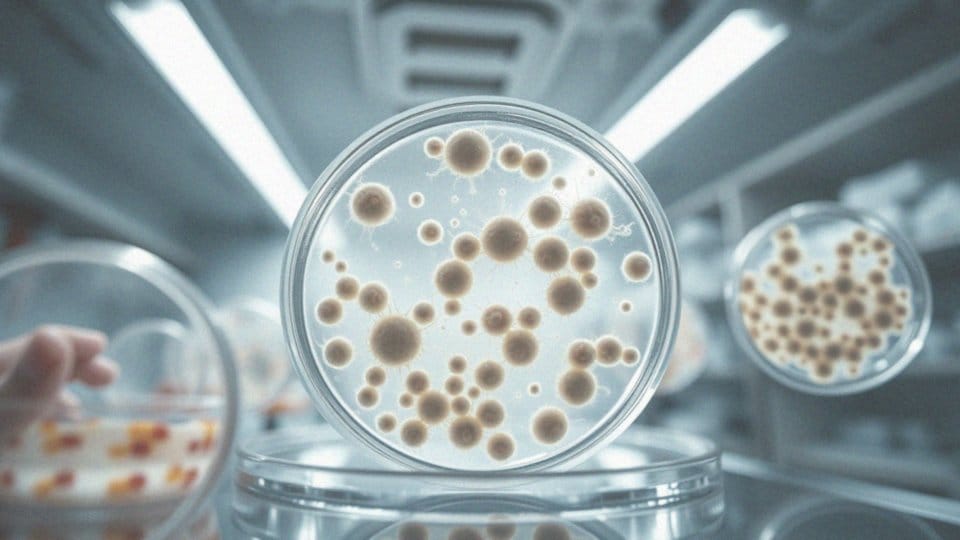

Spis treści
Czy furagina jest lekiem moczopędnym?
Furagina, znana również jako furazydyna, nie należy do grupy leków moczopędnych. Diuretyki, bo tak nazywają się leki zwiększające wydalanie moczu, są wykorzystywane głównie w terapii nadciśnienia tętniczego oraz do łagodzenia zastoju płynów w organizmie. W przeciwieństwie do nich, działanie furaginy skupia się przede wszystkim na hamowaniu rozwoju bakterii.
Lek ten nie przyczynia się do zwiększenia produkcji moczu. Furagina znajduje swoje zastosowanie w leczeniu zakażeń układu moczowego, co klasyfikuje ją jako środek przeciwbakteryjny. W praktyce zmniejsza aktywność wrażliwych bakterii, co z kolei redukuje ryzyko infekcji. Warto jednak podkreślić, że nie jest ona stosowana tam, gdzie konieczne są efekty moczopędne.
Czy furagina ma działanie moczopędne?

Furagina, mimo że może przyczynić się do większej produkcji moczu, nie jest diuretykiem. Jej kluczową funkcją jest działanie przeciwbakteryjne, które hamuje rozwój bakterii odpowiedzialnych za infekcje układu moczowego. Zwiększenie wydalania moczu zwykle następuje po ustąpieniu stanu zapalnego, a nie dzięki samej furaginie.
Lek ten znajduje zastosowanie w terapii infekcji, ale nie jest przeznaczony do leczenia wymagającego diuretyków. Choć wykazuje wysoką skuteczność w walce z konkretnymi bakteriami, jej właściwości moczopędne nie stanowią najistotniejszego aspektu.
Czy furagina jest lekiem przeciwbakteryjnym?
Furagina, znana również jako furazydyna, zalicza się do grupy antybiotyków chemioterapeutycznych. Jest skutecznym środkiem w terapii zakażeń układu moczowego, szczególnie w przypadku zapalenia pęcherza. Działa na zasadzie hamowania wzrostu bakterii, co daje naszemu układowi odpornościowemu szansę na ich eliminację.
To ważny lek w walce z infekcjami dolnych dróg moczowych, gdyż skutecznie zwalcza wrażliwe mikroorganizmy. Warto zauważyć, że chociaż przynosi ulgę, nie zwiększa produkcji moczu i nie działa jako diuretyk. Jej kluczowe zadanie polega na eliminacji patogenów z układu moczowego, co wspomaga organizm w walce z infekcjami.
W jaki sposób furagina działa na bakterie?
Furagina to znany lek chemioterapeutyczny o działaniu przeciwbakteryjnym. Jego efekt opiera się na blokowaniu syntezy białek oraz kwasów nukleinowych w komórkach bakterii, co zaburza kluczowe procesy metaboliczne niezbędne do ich wzrostu i rozmnażania. W rezultacie bakterie mogą obumierać lub ich rozwój ulega znacznemu spowolnieniu.
Co ważne, Furagina skutecznie działa zarówno na bakterie Gram-dodatnie, jak i Gram-ujemne, przez co staje się cennym środkiem w terapii infekcji układu moczowego. Wśród najczęstszych sprawców zapaleń pęcherza znajdują się:
- E. coli,
- Enterococcus faecalis,
- Staphylococcus saprophyticus.
Furagina zwalcza te bakterie z powodzeniem. Wspierając naturalne mechanizmy obronne organizmu, lek pomaga w eliminacji patogenów oraz przyspiesza proces zdrowienia. Jego rola w leczeniu zakażeń układu moczowego ma ogromne znaczenie, ponieważ skutecznie obniża ryzyko poważniejszych infekcji, zwłaszcza w dolnych drogach moczowych.
Jakie bakterie są wrażliwe na działanie furaginy?
Furagina ma działanie przeciwbakteryjne, skutecznie atakując wiele rodzajów bakterii odpowiedzialnych za infekcje układu moczowego. Wśród nich najczęściej występują:
- _Escherichia coli_,
- _Staphylococcus saprophyticus_,
- bakterie Gram-ujemne, takie jak rodzina _Enterobacteriaceae_.
Co więcej, warto zwrócić uwagę na to, że furagina nie radzi sobie tak dobrze z _Pseudomonas aeruginosa_, która jest odporna na wiele dostępnych antybiotyków. To ogranicza jej zastosowanie w przypadku poważniejszych zakażeń. Badania jasno pokazują, że furagina przyczynia się do złagodzenia objawów infekcji, co czyni ją wartościowym lekiem w terapii przeciwbakteryjnej.
Kiedy stosuje się furaginę w leczeniu zakażeń układu moczowego?
Furagina to lek powszechnie stosowany w terapii infekcji układu moczowego, w szczególności w przypadku zapalenia pęcherza. Jest skuteczna w walce z bakteriami wrażliwymi na jej działanie, takimi jak:
- Escherichia coli,
- Staphylococcus saprophyticus.
Jej mechanizm polega na zahamowaniu wzrostu i rozmnażania tych mikroorganizmów, co umożliwia organizmowi ich efektywne usunięcie. Liczne badania kliniczne potwierdzają wysoką skuteczność furaginy w leczeniu zakażeń dolnych dróg moczowych. Warto dodać, że oprócz działania terapeutycznego, lek ten ma również zastosowanie w profilaktyce, pomagając unikać nawrotów infekcji, co czyni go cennym wsparciem dla osób, które często borykają się z tego rodzaju problemami.
Niemniej jednak, przed rozpoczęciem kuracji zawsze warto skonsultować się z lekarzem, który odpowiednio dobierze dawkowanie oraz czas trwania leczenia, dostosowując je do specyfiki danego zakażenia.
Czy furagina jest skuteczna w leczeniu wszystkich infekcji układu moczowego?
Furagina to skuteczny środek przeciwko wielu infekcjom układu moczowego, jednak nie jest wolna od ograniczeń. Działa na bakterie takie jak:
- Escherichia coli,
- Staphylococcus saprophyticus,
które często są odpowiedzialne za zapalenia pęcherza. Dzięki temu lek sprawdza się w przypadku niepowikłanych zakażeń wywołanych tymi mikroorganizmami. Z drugiej strony, w przypadkach bardziej skomplikowanych, zwłaszcza gdy źródłem są oporne bakterie, takie jak Pseudomonas aeruginosa, jego efektywność może znacząco maleć. Te mikroorganizmy często wykazują odporność na furaginę, co wymaga zastosowania innych antybiotyków.
Sukces terapii z użyciem tego leku zależy więc od trafnego określenia patogenu oraz jego reakcji na furaginę. W związku z tym lekarze mogą decydować się na dodatkowe badania, aby zweryfikować, czy furagina będzie odpowiednim wyborem w danej sytuacji. Niekiedy może być zasadne sięgnięcie po bardziej szerokospektralne środki przeciwbakteryjne. Skuteczne leczenie zakażeń układu moczowego wymaga zatem precyzyjnego dopasowania terapii do konkretnego patogenu i charakteru infekcji.
Jakie są objawy infekcji układu moczowego, które mogą wymagać stosowania furaginy?
Objawy infekcji układu moczowego, które mogą wymagać zastosowania furaginy, obejmują kilka charakterystycznych sygnałów. Należy zwrócić uwagę na:
- częste i bolesne oddawanie moczu,
- pieczenie w trakcie mikcji,
- nagłe parcie na mocz.
To zdecydowane oznaki, które powinny skłonić do zastanowienia się nad leczeniem tą substancją. Dodatkowo, ból w podbrzuszu oraz:
- nietypowy zapach moczu,
- zmiana koloru moczu.
Są to również sygnały, które mogą świadczyć o infekcji. W niektórych przypadkach pacjenci zauważają ogólne osłabienie lub gorączkę. Monitorowanie tych symptomów jest niezwykle istotne, dlatego warto skonsultować się z lekarzem. Odpowiednie badania moczu mogą potwierdzić występowanie infekcji i pomóc w opracowaniu adekwatnej strategii leczenia. W ramach wskazanej terapii furagina może być użyta jako skuteczny środek przeciwdziałający bakteriom w infekcjach układu moczowego.
Jakie są wskazania do zastosowania furaginy?
Furagina to lek, który przede wszystkim wykorzystuje się w terapii ostrych i przewlekłych zakażeń dolnych dróg moczowych, jak na przykład:
- zapalenie pęcherza moczowego,
- eliminowanie bakterii,
- zapobieganie nawrotom zakażeń układu moczowego.
Jest skuteczna w eliminowaniu bakterii, w tym Escherichia coli oraz Staphylococcus saprophyticus, które są na nią wrażliwe. Co więcej, lek ten sprawdza się także w zapobieganiu nawrotom zakażeń układu moczowego, co czyni go istotnym elementem terapii dla osób borykających się z tymi schorzeniami. Przed rozpoczęciem kuracji zaleca się konsultację z lekarzem. Warto również przeprowadzić odpowiednie badania diagnostyczne, aby potwierdzić wystąpienie infekcji oraz ocenić, jak bakterie reagują na furaginę. Należy jednak pamiętać, że nie jest on efektywny wobec wszystkich patogenów, zwłaszcza szczepów odpornych, takich jak Pseudomonas aeruginosa. Z tego powodu dokładne zidentyfikowanie sprawcy zakażenia oraz dostosowanie leczenia do indywidualnej sytuacji pacjenta ma ogromne znaczenie dla efektywności terapii zakażeń układu moczowego.
Jakie działania niepożądane mogą wystąpić po zażyciu furaginy?
Po przyjęciu furaginy warto być czujnym na różnorodne skutki uboczne, które mogą się pojawić. Do najczęściej występujących należą:
- nudności,
- bóle głowy,
- zawroty głowy,
- problemy żołądkowo-jelitowe, takie jak biegunka czy wymioty,
- ból brzucha.
Choć reakcje alergiczne, takie jak wysypka czy świąd, są rzadsze, również wymagają uwagi. W rzadkich przypadkach mogą wystąpić poważniejsze komplikacje, na przykład:
- polineuropatia, związana z uszkodzeniem nerwów obwodowych,
- zaburzenia funkcji wątroby.
Jeśli zaobserwujesz jakiekolwiek niepokojące objawy, koniecznie skonsultuj się z lekarzem. Dzięki temu będzie można ocenić, czy należy kontynuować leczenie, czy może lepiej rozważyć zmianę leku.
Jakie są skutki uboczne stosowania furaginy?
Furagina może prowadzić do różnych efektów ubocznych, które warto śledzić. Najczęściej pacjenci skarżą się na:
- nudności,
- bóle głowy,
- zawroty głowy.
W trakcie leczenia mogą także wystąpić problemy związane z układem pokarmowym, takie jak:
- biegunka,
- wymioty,
- bóle brzucha.
Choć rzadziej, niektórzy mogą doświadczać reakcji alergicznych, na przykład w postaci:
- wysypek,
- swędzenia.
Istotnym, aczkolwiek mniej powszechnym skutkiem ubocznym, jest polineuropatia, która oznacza uszkodzenie nerwów obwodowych. Długotrwałe stosowanie tego leku może także wywołać:
- zaburzenia hematologiczne,
- nieprawidłowości w wynikach badań laboratoryjnych,
- podwyższony poziom enzymów wątrobowych.
Dlatego niezwykle ważne jest, aby uważnie obserwować swój stan zdrowia w trakcie terapii. W przypadku wystąpienia jakichkolwiek niepokojących symptomów, należy bezzwłocznie zasięgnąć porady lekarza, aby podjąć odpowiednie działania w zakresie leczenia.
Czy furagina wpływa na produkcję moczu?

Furagina jest znana z właściwości przeciwbakteryjnych, jednak nie ma wpływu na produkcję moczu. Nie sytuuje się w kategorii leków moczopędnych, więc nie zwiększa ilości wydalanego moczu, tak jak diuretyki to czynią.
Jej głównym zadaniem jest zwalczanie bakterii w układzie moczowym, a nie pobudzanie diurezy. W trakcie leczenia infekcji, na przykład zapalenia pęcherza, zwiększona objętość moczu może wystąpić jedynie w momencie ustępowania stanu zapalnego wywołanego przez patogeny. Chociaż poprawa w wydalaniu moczu może wystąpić w wyniku działania furaginy, nie jest to jej pierwotny skutek.
Dlatego nie jest zalecana do terapii, która ma na celu zwiększenie produkcji moczu. Przykładowo, w przypadku obrzęków czy nadciśnienia tętniczego nie jest to optymalny wybór.
Kluczowa skuteczność furaginy polega na eliminacji bakterii oraz wspieraniu organizmu w walce z infekcją, co pozytywnie wpływa na ogólny stan zdrowia pacjenta. Furagina przynosi najlepsze rezultaty, gdy jej celem jest zwalczanie infekcji, a nie stymulowanie diurezy.